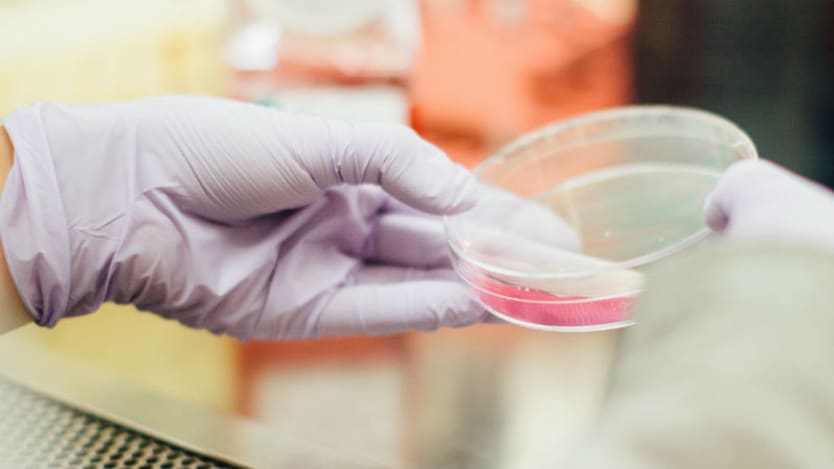

A master’s degree in public or global health is the go-to degree for anyone interested in pursuing a global health career. MPH programs largely attract graduates from life sciences and allow them to study further topics such as health and social behavior, global health, health policy, and environmental health.
Devex asked global development professionals for their thoughts on their postgraduate degree. All of respondents who held a master’s in public or global health said their degree was worth the investment in time and money. Here is what else they had to say about the MPH.
More on popular degree programs:
Career opportunities
While some MPH graduates come from a clinical practitioner background, such as nursing, the study of areas such as policy and global health issues mean this degree also appeals to professionals interested in the international development sector. Potential careers include working for health ministries, humanitarian organizations, government agencies, or research institutions.
Of the MPH graduates that Devex spoke to, 76 percent said they were “satisfied” or “strongly satisfied” with their employment opportunities immediately after graduation, and 88 percent of that same group were “satisfied” or “strongly satisfied” that their degree would lead to long-term career advancement opportunities.
Kristina Granger, who graduated with a bachelor's in political science and women’s studies, returned to school to pursue a MPH and is now a senior social and behavior change advisor for USAID. With a strong interest in child and infant health, Granger’s decision was also based on the trends at that time, which she says showed that health was getting a lot of funding. “It seemed like something that there was a lot of work to do — a lot of important work — and people were putting funding towards it,” says Granger, adding that she felt “confident that I would have a long career in this.”
83 percent said that their degree had given them opportunities to make a positive societal contribution since graduating.
—Compensation
77 percent of this group were “satisfied” or “strongly satisfied” with their immediate compensation levels upon graduation. This group were also positive when it came to long-term earning potential for MPH graduates, 71 percent said they were “satisfied” or “strongly satisfied.”
Job happiness
MPH graduates were generally happy with their work-life balance, 76 percent of the professionals we spoke to felt “satisfied” or “strongly satisfied.” Of this group, 83 percent said that their degree had given them opportunities to make a positive societal contribution since graduating.
Want to see how different degree programs stack up against each other? Use this interactive chart to compare 10 top degree programs for a global development career and see how graduates rate them on everything from compensation to work-life balance.
Where can this degree lead you?
Granger felt her master's degree, from George Washington University, gave her a good theoretical underpinning for the work she does now, particularly “understanding the evolution of the science of behavior change.” An MPH program can equip graduates with specialized skills and subject-specific expertise.
While it was already an area of interest to her, Granger decided during her studies that she had a real passion for maternal and child nutrition and breastfeeding promotion. Granger was a part of the health communication and behavioral change track within her MPH and says her interest in these specific issues is something that “just happened through her studies.” Maternal and child nutrition became the focus of all of her research papers and projects and to this day she continues to work on these issues.
“Understanding the data collection, design, and analysis and being able to interpret data in journal articles is really critical.”
— Kristina Granger, master’s in public health from George Washington UniversityThe MPH can also push students a little out their comfort in forcing them to study a range of technical courses. Granger described her MPH course as “pretty rigid” and consisting of just two electives with many more compulsory courses. She says that while it was frustrating at the time having to study courses that you would have not otherwise chosen, “it really does give you a good, well-balanced education.” One example was a compulsory quantitative data class, which turned out to be “invaluable” to Granger’s current work dealing with data on a daily basis. “Understanding the data collection, design, and analysis and being able to interpret data in journal articles is really critical,” says Granger, adding that not having those skills would have been detrimental to her career.
You know you need a postgraduate degree to advance in a global development career, but deciding on a program, degree, and specialization can be overwhelming. In partnership with the Association of Professional Schools of International Affairs (APSIA), Duke Center for International Development (DCID) at Duke University, Duke Kunshan University, the Online Master of Public Health (MPH) at George Washington University, and the MPA/ID Program at Harvard Kennedy School, we are digging into all things graduate school and global development in a weeklong series called Grad School Week. Join online events and read more advice on pursuing a postgraduate education here.
Search for articles
Most Read
- 1
- 2
- 3
- 4
- 5


